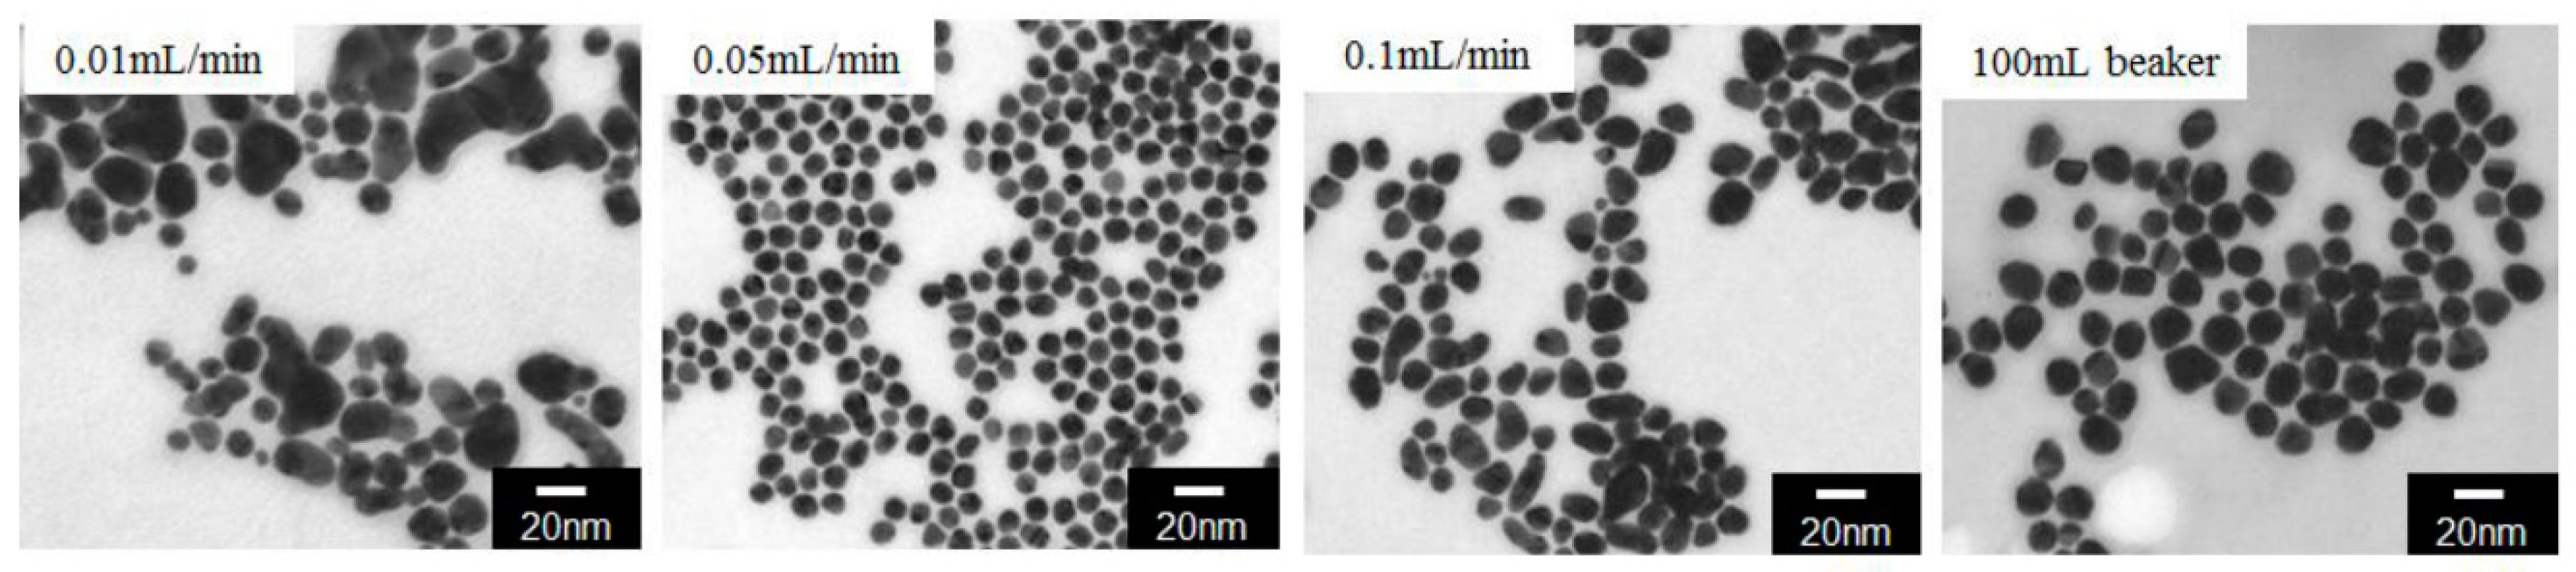

Analysis of Synthesis Mechanism of Gold Nanoparticles Using Glass Microfluidics †
Abstract
:1. Introduction
2. Materials and Methods
2.1. Glass Device
2.2. Synthesis
2.3. Characterization
3. Results and Discussion
3.1. Absorption Spectrum and Mixing Time
3.2. Particle Size Distribution
4. Conclusions
Acknowledgments
Conflicts of Interest
References
- Bolduc, O.R.; Masson, J.F. Advances in Surface Plasmon Resonance Sensing with Nanoparticles and Thin Films: Nanomaterials, Surface Chemistry, and Hybrid Plasmonic Techniques. Anal. Chem. 2011, 83, 8057–8062. [Google Scholar] [CrossRef]
- Lamer, V.K.; Dinegar, R.H. Theory, Production and Mechanism of Formation of Monodispersed Hydrosols. J. Am. Chem. Soc. 1950, 72, 4847–4854. [Google Scholar] [CrossRef]
- Yagyu, H.; Sugano, K.; Hayashi, S.; Tabata, O. Micropowder Blasting using Nanoparticles Dispersed Polymer Mask for Rapid Prototyping of Glass Chip. J. Micromech. Microeng. 2005, 15, 1236–1241. [Google Scholar] [CrossRef]

| Reagent | Solution-A | Solution-B |
|---|---|---|
| HAuCl4·4H2O | 1 g | - |
| Sodium citrate acid (33.7 mM) | - | 4.0 mL |
| Tannic acid (5.82 mM) | - | 0.1 mL |
| H2O | 79 mL | 75.9 mL |
Publisher’s Note: MDPI stays neutral with regard to jurisdictional claims in published maps and institutional affiliations. |
© 2018 by the authors. Licensee MDPI, Basel, Switzerland. This article is an open access article distributed under the terms and conditions of the Creative Commons Attribution (CC BY) license (https://creativecommons.org/licenses/by/4.0/).
Share and Cite
Wang, Y.; Tanabe, Y.; Yagyu, H. Analysis of Synthesis Mechanism of Gold Nanoparticles Using Glass Microfluidics . Proceedings 2018, 2, 702. https://doi.org/10.3390/proceedings2130702
Wang Y, Tanabe Y, Yagyu H. Analysis of Synthesis Mechanism of Gold Nanoparticles Using Glass Microfluidics . Proceedings. 2018; 2(13):702. https://doi.org/10.3390/proceedings2130702
Chicago/Turabian StyleWang, Yuanwei, Yu Tanabe, and Hiromasa Yagyu. 2018. "Analysis of Synthesis Mechanism of Gold Nanoparticles Using Glass Microfluidics " Proceedings 2, no. 13: 702. https://doi.org/10.3390/proceedings2130702
APA StyleWang, Y., Tanabe, Y., & Yagyu, H. (2018). Analysis of Synthesis Mechanism of Gold Nanoparticles Using Glass Microfluidics . Proceedings, 2(13), 702. https://doi.org/10.3390/proceedings2130702

